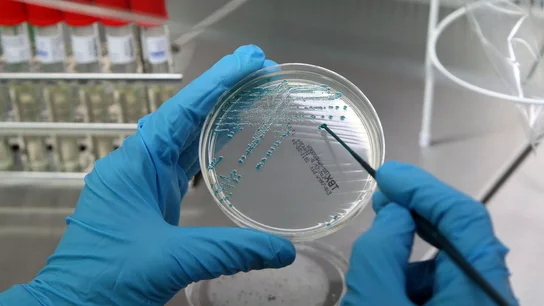

TODAVÍA ESTÁ EN UNA FASE INCIAL
Éxito contra el cáncer en la primera inmunoterapia española: reduce el tamaño del tumor en un 17% y lo controla en un 58% de los pacientes
La primera inmunoterapia contra el cáncer desarrollada en España no provoca efectos secundarios graves, reduce el tamaño del tumor en el 17% de los casos y controla la enfermedad en otro 58%. Los científicos ahora investigan si hay más posibilidad de eficacia, la duración de la misma y si podría servir en pacientes en los que no han funcionado otras inmunoterapias.
La primera inmunoterapia contra el cáncer desarrollada íntegramente en España ha demostrado, en un ensayo clínico con pacientes de melanoma, tumor de pulmón y renal, que además de "no provocar efectos secundarios graves es capaz de controlar la enfermedad en un 58 % de los casos y de reducir el tamaño tumoral en un 17 %".
Según el Hospital Gregorio Marañón de Madrid y la Clínica Universidad de Navarra, la terapia con BO-112 ha concluido el primer ensayo clínico de seguridad en pacientes y "se puede decir que este fármaco español es seguro y, además, en datos preliminares, muestra eficacia ante determinados tipos de cáncer".
"Es un gran salto para esta investigación promovida y desarrollada por investigadores de nuestro país y que abre nuevas posibilidades de tratamiento", señalan ambos centros en un comunicado conjunto. La inmunoterapia basada en anticuerpos anti PD-1/PD-L1 ha revolucionado el pronóstico de los pacientes, aunque no todos se benefician de estos tratamientos. De ahí "las estrategias de combinación de varios fármacos", explica la nota.
En el ensayo con la molécula BO-112, "una terapia intratumoral con efecto inmunomodulador desarrollada íntegramente en España", se han tratado 28 pacientes con tumores sólidos en los que se observó "una reducción objetiva del tamaño tumoral", si bien estos resultados, presentados en el último Congreso Europeo de Oncología celebrado en Múnich, aún deben considerarse como "muy preliminares”, según el oncólogo del Gregorio Marañón, Iván Márquez Rodas.
Un tercer hospital, el Ramón y Cajal de Madrid, ha participado en el estudio clínico, al que se han incorporado siete hospitales que están reclutando pacientes.
“Nuestra intención es seguir avanzando en el conocimiento del perfil de seguridad, mecanismos de acción de BO-112, así como averiguar si hay más eficacia y cuánto de duradera es ésta en pacientes a los que no les ha funcionado una terapia previa con anti PD-1", agrega Márquez.
"Es un trabajo pionero que combina inmunterapia local y sistémica", cuya filosofía consiste en "intentar convertir a algunas de las lesiones tumorales en un tejido inmunogénico que despierte una respuesta inmunitaria, ayudando a la respuesta inmune en el resto del organismo", explica Ignacio Melero, de la Clínica de Navarra.
“En los modelos animales hemos comprobado que el tratamiento con esta doble aproximación es sinérgico y los datos preliminares del ensayo indican que una situación similar puede darse en los pacientes. Hay varios fármacos que usan esta estrategia de vacunación 'in situ', pero BO-112 puede ser el más potente”, afirma.
Los investigadores continuarán el estudio, promovido por empresa biotecnológica española Bioncotech Therapeutics, hasta al menos alcanzar 30 pacientes tratados con la combinación de BO-112 y anticuerpos anti PD-1 (nivolumab o pembrolizumab), añadiéndose para esta fase otros centros españoles.